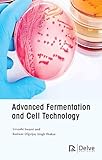
Cover image

Advanced fermentation and cell technology Swami, Urvashi.
Publisher: Delve Digvijay Singh Thakur. ; 2022Description: xxii, 252 pagesISBN: 978-1-77469-100-7Subject(s): Cell cultureDDC classification: 660.62 S9719 2022| Item type | Current location | Home library | Collection | Call number | Status | Date due | Barcode | Item holds |
|---|---|---|---|---|---|---|---|---|
Book
|
Sibalom | Sibalom MCIR | Main-Circulation | 660.62 S9719 2022 (Browse shelf) | Available | UAMAIN 33775 |
Total holds: 0
Browsing Sibalom Shelves , Shelving location: MCIR , Collection code: Main-Circulation Close shelf browser
|
|
|
|
|
|
|
||
| 660.6 T433 2018 Introduction to biotechnology | 660.6 T433 2018 Introduction to biotechnology | 660.62 P2381 2020 Fungal biotechnology | 660.62 S9719 2022 Advanced fermentation and cell technology | 660.650952 M1421 1992 Attitudes to genetic engineering : Japanese and international comparisons | 660.650952 M1421 1992 Attitudes to genetic engineering : Japanese and international comparisons | 661.2 G112 2013 A handbook of laboratory solutions/ |
600 Technology (App Sciences)
Book
There are no comments for this item.